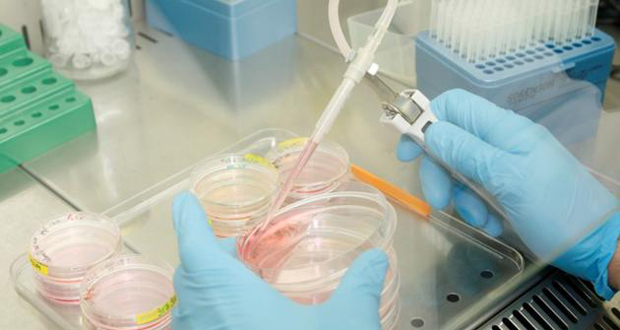

Reuters

20 décembre 2014 12:07
Les USA accusent Pyongyang, Obama juge que Sony a fait une erreur

20 décembre 2014 08:52
Un record pour les pertes civiles cette année en Afghanistan

20 décembre 2014 03:46
Les USA accusent Pyongyang, Obama juge que Sony a fait une erreur

20 décembre 2014 03:42
Séisme de 5,6 en Guadeloupe, pas de dégâts signalés

19 décembre 2014 07:41
Tuerie à l'arme blanche en Australie, huit enfants morts

18 décembre 2014 14:03
Vladimir Poutine assure que l'économie russe va se redresser
18 décembre 2014 11:51
La CEJ ouvre la voie à des brevets sur les cellules souches

18 décembre 2014 06:41
La disette menace les pays touchés par Ebola

17 décembre 2014 08:13
